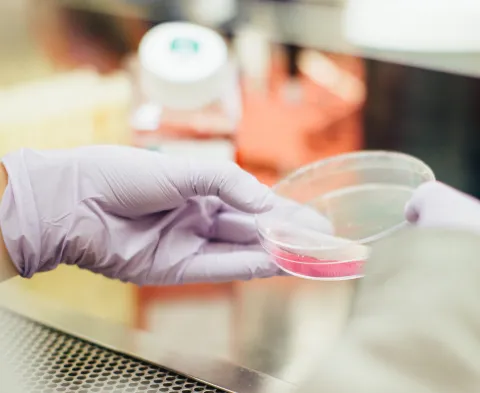
Stock image of a researcher's gloved hand holding a small circular glass container with a pink substance inside.

Technical specification
Molecular biology
- Cloning with standard restriction digestion and ligation techniques
- Cloning with sequence ligation-independent cloning (SLIC) techniques
- Design of synthetic DNA with sequence optimisation; PCR, Inverse-PCR, mutagenesis
- Making of high competent bacteria for cloning (JM109 and others)
- Bacterial vectors: pET (His6), pGEX (GST), pOPIN (His6, GST, MBP, SUMO, TG, NusA, Thioredoxin)
- Insect vectors: pMT-Puro, pFastBac, pOPIN
- Mammalian vectors: pcDNA3, pDSG (His6, TwinStrep), pCI-Puro, pEE6.4
Expression systems
Bacteria
Pros: High levels of protein, quick, low cost, scalable, simple culture conditions.
Cons: Difficult with large proteins, proteins can be misfolded, lack of post-translational modifications.
- E. coli BL21 Strains DE3, pLys, pLacI, Rosetta2
- Culture in LB and Terrific Broth media
- IPTG induction and auto-induction
Insect cells
Pros: Closer to mammalian protein processing.
Cons: More demanding culture conditions than bacteria, production of baculovirus can be time consuming.
- Stable transfection of S2 cells with copper-inducible system
- Baculovirus system with Sf9 and High5 cells
Mammalian cells
Pros: Natural folding, post-translational modifications, pyrogen-free
Cons: Expensive
- HEK MEXi293E cells - transient expression
- ExpiCHO cells - transient expression
Protein purification
- Refolding of insoluble proteins expressed in bacteria
- Affinity chromatography for tagged proteins (His6, GST, MBP, TwinStrep), antibodies and Fabs
- Ion exchange chromatography
- Size exclusion chromatography
Protein modification
- Tag removal: TEV, H3C, SUMO proteases
- Labelling of proteins and antibodies
- Endotoxin removal from protein sample
Specific equipment
- MaxQ 6000 Shaker incubators for bacterial expression (room temperature – 37C)
- MaxQ 6000R Refrigerated shaker incubator for bacterial expression (4C – 37C)
- Infors HT Multitron shaker incubators for mammalian transient expression
- Infors HT Minitron shaker incubator for insect expression
- Cytiva Akta PrimePlus protein purification systems
- Bio-Rad NGC Protein purification system
- Amicon stirred cell concentrator
Applications
- Flow cytometry
- Fluorescent microscopy
- Protein-protein interaction – BiaCore, ELISA
- Enzymatic assays
- Cell culture
- Mouse work
- Protein Structure in collaboration with IfLS groups
Examples of recombinant proteins produced by the Protein Facility
- Tag removal: His6-H3C / GST-H3C, His6-TEV and SUMO proteases
- Biotinylation ligase Bir A enzyme
- Annexin V-FITC and Annexin V-APC
- MHC I tetramers
- Cytokines and interleukins
- Antibodies, Fabs and ScFv
- Tailored proteins